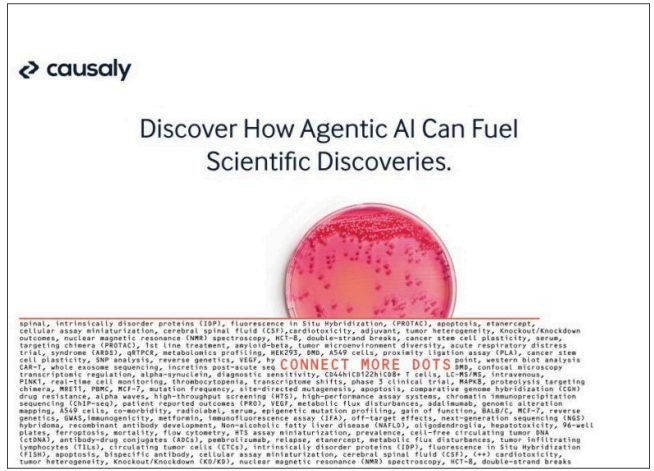
{{brizy_dc_image_alt imageSrc=

Address 3 central performance engineering challenges with browser-based testing

If your page takes longer than 6 seconds to load, you can expect 50% of users to abandon it. As browser-based applications grow more sophisticated, more web elements contribute to your enduser’s experience – and what could be slowing it down.
Accurately measuring end-user response time is increasingly critical to customer growth and retention – and it can’t be achieved with protocol-based testing alone. A holistic approach can improve the effectiveness of your overall performance testing strategy and help you overcome common challenges.
Read this white paper to learn how to:
- Differentiate between end-user and transaction response time
- Overcome the scale limitations of protocol-based testing without breaking the bank
- Test complex, dynamic browser applications on a tight timeline
Please complete the form to access/download the content